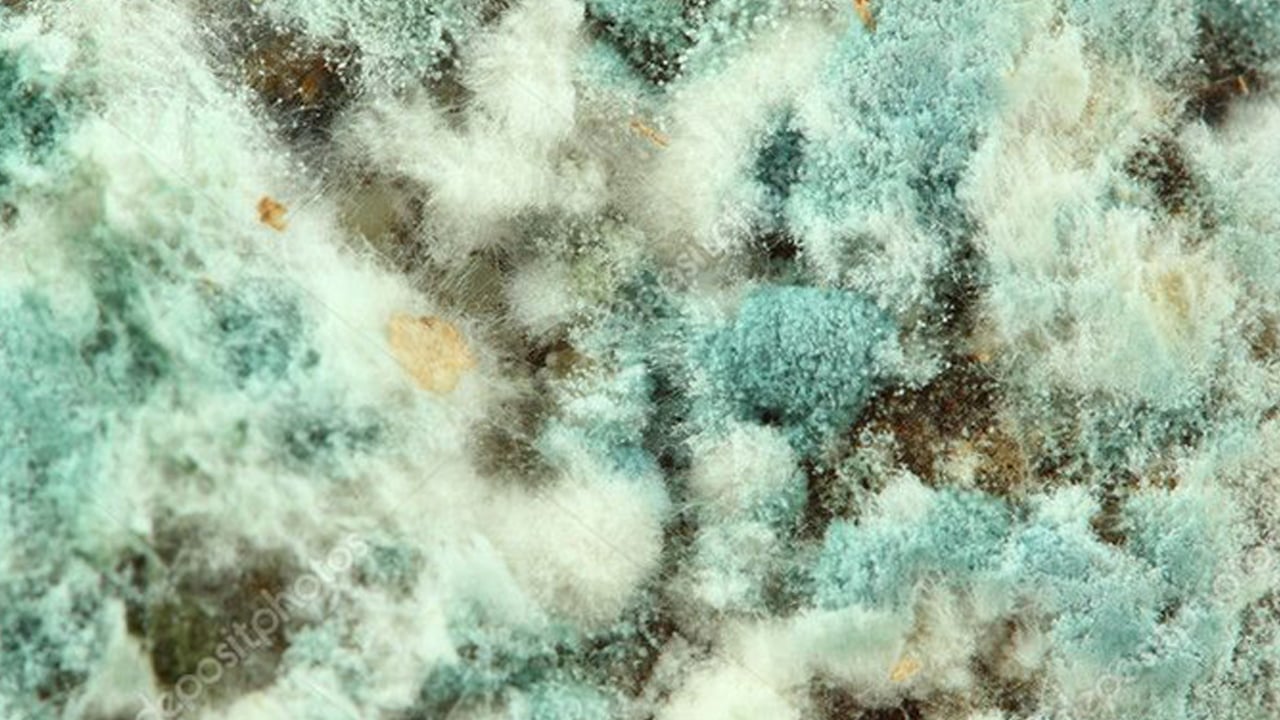
Foto - Yatağı haftada 1 kez yıkayın: Küften beslenen mantarları beslediği ortaya çıktı! Doktor vatandaşları uyardı!

Havaların serinlemeye başladığı, kapalı alanlarda daha fazla vakit geçirdiğimiz sonbahar ayları, birçok kişi için alerjik hastalıkların yeniden alevlendiği bir dönem anlamına geliyor. Bahar aylarında polenler nedeniyle artan alerjik şikayetler, sonbaharda bu kez küf mantarları, ev tozu akarları ve nemli ortamlar yüzünden yeniden ortaya çıkıyor. Alerjinin kimi zaman yıl boyu devam edebilen bir durum olduğunu belirten Medline Adana Hastanesi Göğüs Hastalıkları Uzmanı Dr. Mustafa Faysal Baysal, bu problemin erken tanı ve uygun tedaviyle kontrol altına alınabileceğini söyledi. Küf mantarları ve ev tozu akarları alerjiyi tetikliyor Sonbaharla birlikte hava sıcaklıklarının düşmesi ve yağışların artmasının iç mekanlarda nem oranını yükselttiğini belirterek, Dr. Baysal, "Bu durum da küf mantarlarının ve ev tozu akarlarının çoğalması için elverişli bir ortam oluşuyor. Küf mantarları genellikle banyo, mutfak, bodrum gibi nemli bölgelerde duvarlarda veya mobilya arkasında görünmeden çoğalabiliyor. Solunum yoluyla bu mantar sporlarına maruz kalan kişilerde burun akıntısı, hapşırık, geniz kaşıntısı, gözlerde sulanma ve öksürük gibi belirtiler ortaya çıkabiliyor. Ev tozu akarları ise özellikle yünlü halılar, pelüş oyuncaklar, yatak ve yastık içlerinde yaşıyor. Havalandırılmayan odalarda biriken bu mikroskobik canlılar da solunum yoluyla alerjik reaksiyonları tetikleyebiliyor. Bu sorundan korunmak için, evlerin sık sık havalandırılması, halıların düzenli olacak şekilde süpürülmesini ve yatak takımlarının yüksek ısıda yıkanması gerekiyor" dedi.